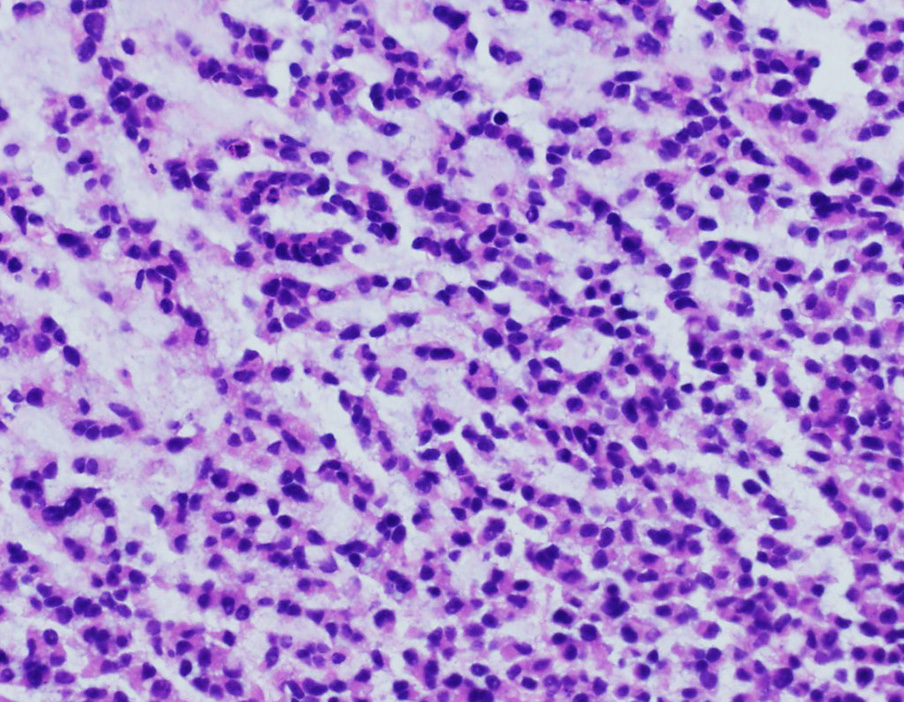
Pic 4

Case History
A 45-year-old woman presented with a rapidly growing thigh mass. A biopsy showed a small, blue, round cell tumor. The lesional cells were positive for WT-1 and negative for cytokeratin and desmin.
What is the diagnosis?
- Extraskeletal myxoid chondrosarcoma
- Ewing sarcoma
- C. Myxoid liposarcoma
- CIC-rearranged sarcoma
The answer is “D”,CIC-rearranged sarcoma
CIC-rearranged sarcoma is a recently established translocation-associated round cell sarcoma. The most common fusion partner is DUX4.It primarily occur in the deep soft tissue of the limbs and trunk, less commonly affect the head and neck, retroperitoneum, pelvis and visceral organs, and rarely arise in bone. There is a wide age distribution at presentation but more commonly occur in young adults.
Histologically, CIC-rearranged sarcomas are typically composed of solid sheets of small round cells, with a lobulated grow pattern. Focal myxoid stroma is a common feature. There is typically minor (or less frequent moderate) nuclear pleomorphism. These tumors may have variable CD99 immunoreactivity. Expression of WT1 and ETV4 is reportedly seen in 90-100% of tumors thus is useful in distinguishing CIC-rearranged sarcomas from their histologic mimickers. Most CIC-rearranged tumors have a dismal response to Ewing sarcoma regiments and have aggressive outcomes.
Extraskeletal myxoid chondrosarcoma usually occurs in adults, mostly arises in the deep soft tissues of the proximal extremities. The tumor typically has a multinodular architecture, with abundant myxoid or chondromyxoid matrix. The tumor cells form cords, and small clusters, with minimal cytologic atypia. Most of these tumors demonstrate t(9;22)(q22;q12) or less frequently t(9;17)(q22;q11) resulting gene fusions of NR4A3-EWSR1 or NR4A3-TAF15.
Ewing sarcomas are histologic mimickers of CIC-rearranged sarcoma. It is driven by pathognomonic and etiological TEF-ETS gene fusions, the most common alteration being EWSR1-FLI1 translocation.
Myxoid liposarcomausually occurs in young adults, mostly arises in the deep soft tissues of the extremities. The tumor typically has a nodular growth pattern, with a prominent myxoid stroma and delicate, arborizing, “chicken-wire” vasculature, and often contains “pulmonary edema”-like areas. There is a mixture of small, round, blue cells and small, signet-ring lipoblasts. Myxoid liposarcoma is characterized by t(12;16)(q13;p11) that results in FUS-DDIT3 gene fusion, present in >95% of cases. Rarely, t(12;22)(q13;q12) EWSR1-DDIT3 can be seen.